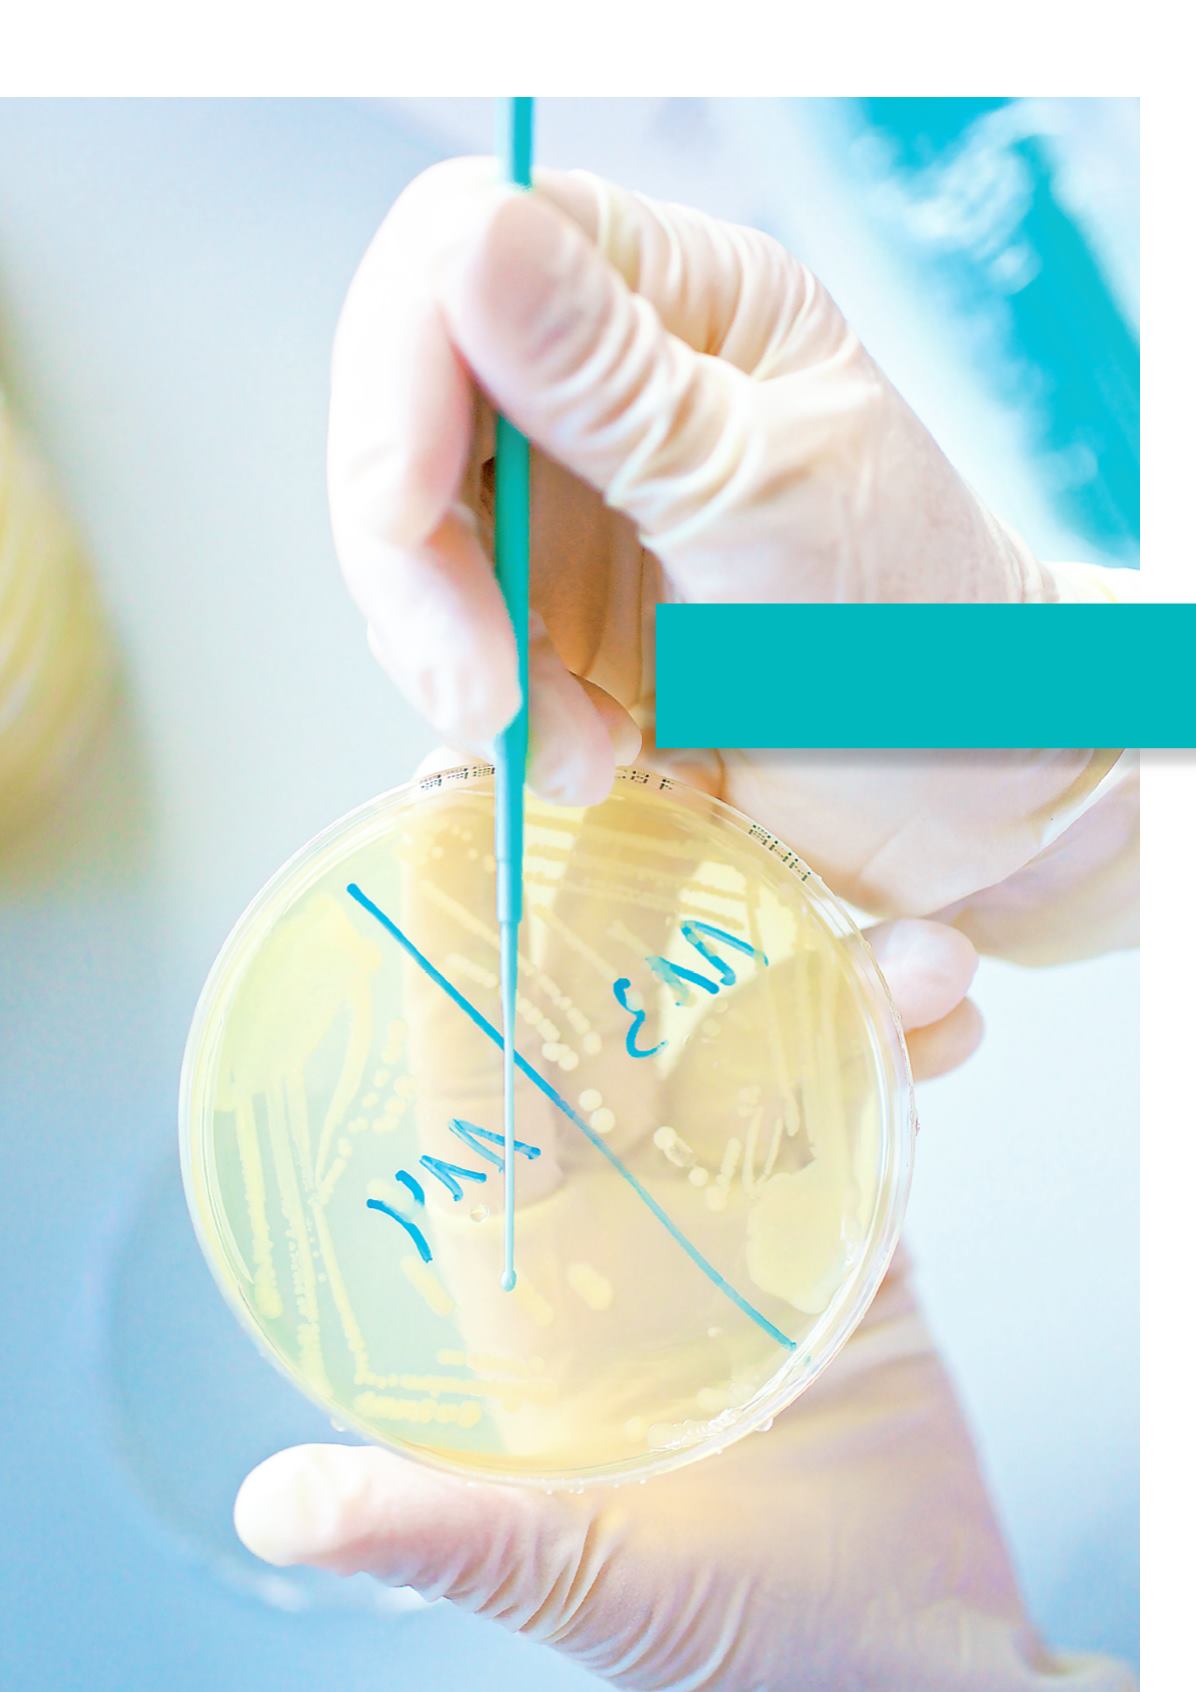

31
Schwerpunkte 2013 | Antibiotikaresistenz
Am Nationalen Referenzlabor für Antibiotika-
resistenz untersucht das BfR jährlich mehrere
Tausend Erreger-Isolate auf ihre Resistenz-
eigenschaften. Für den Test werden die Erreger
zunächst auf Nährböden angezüchtet.